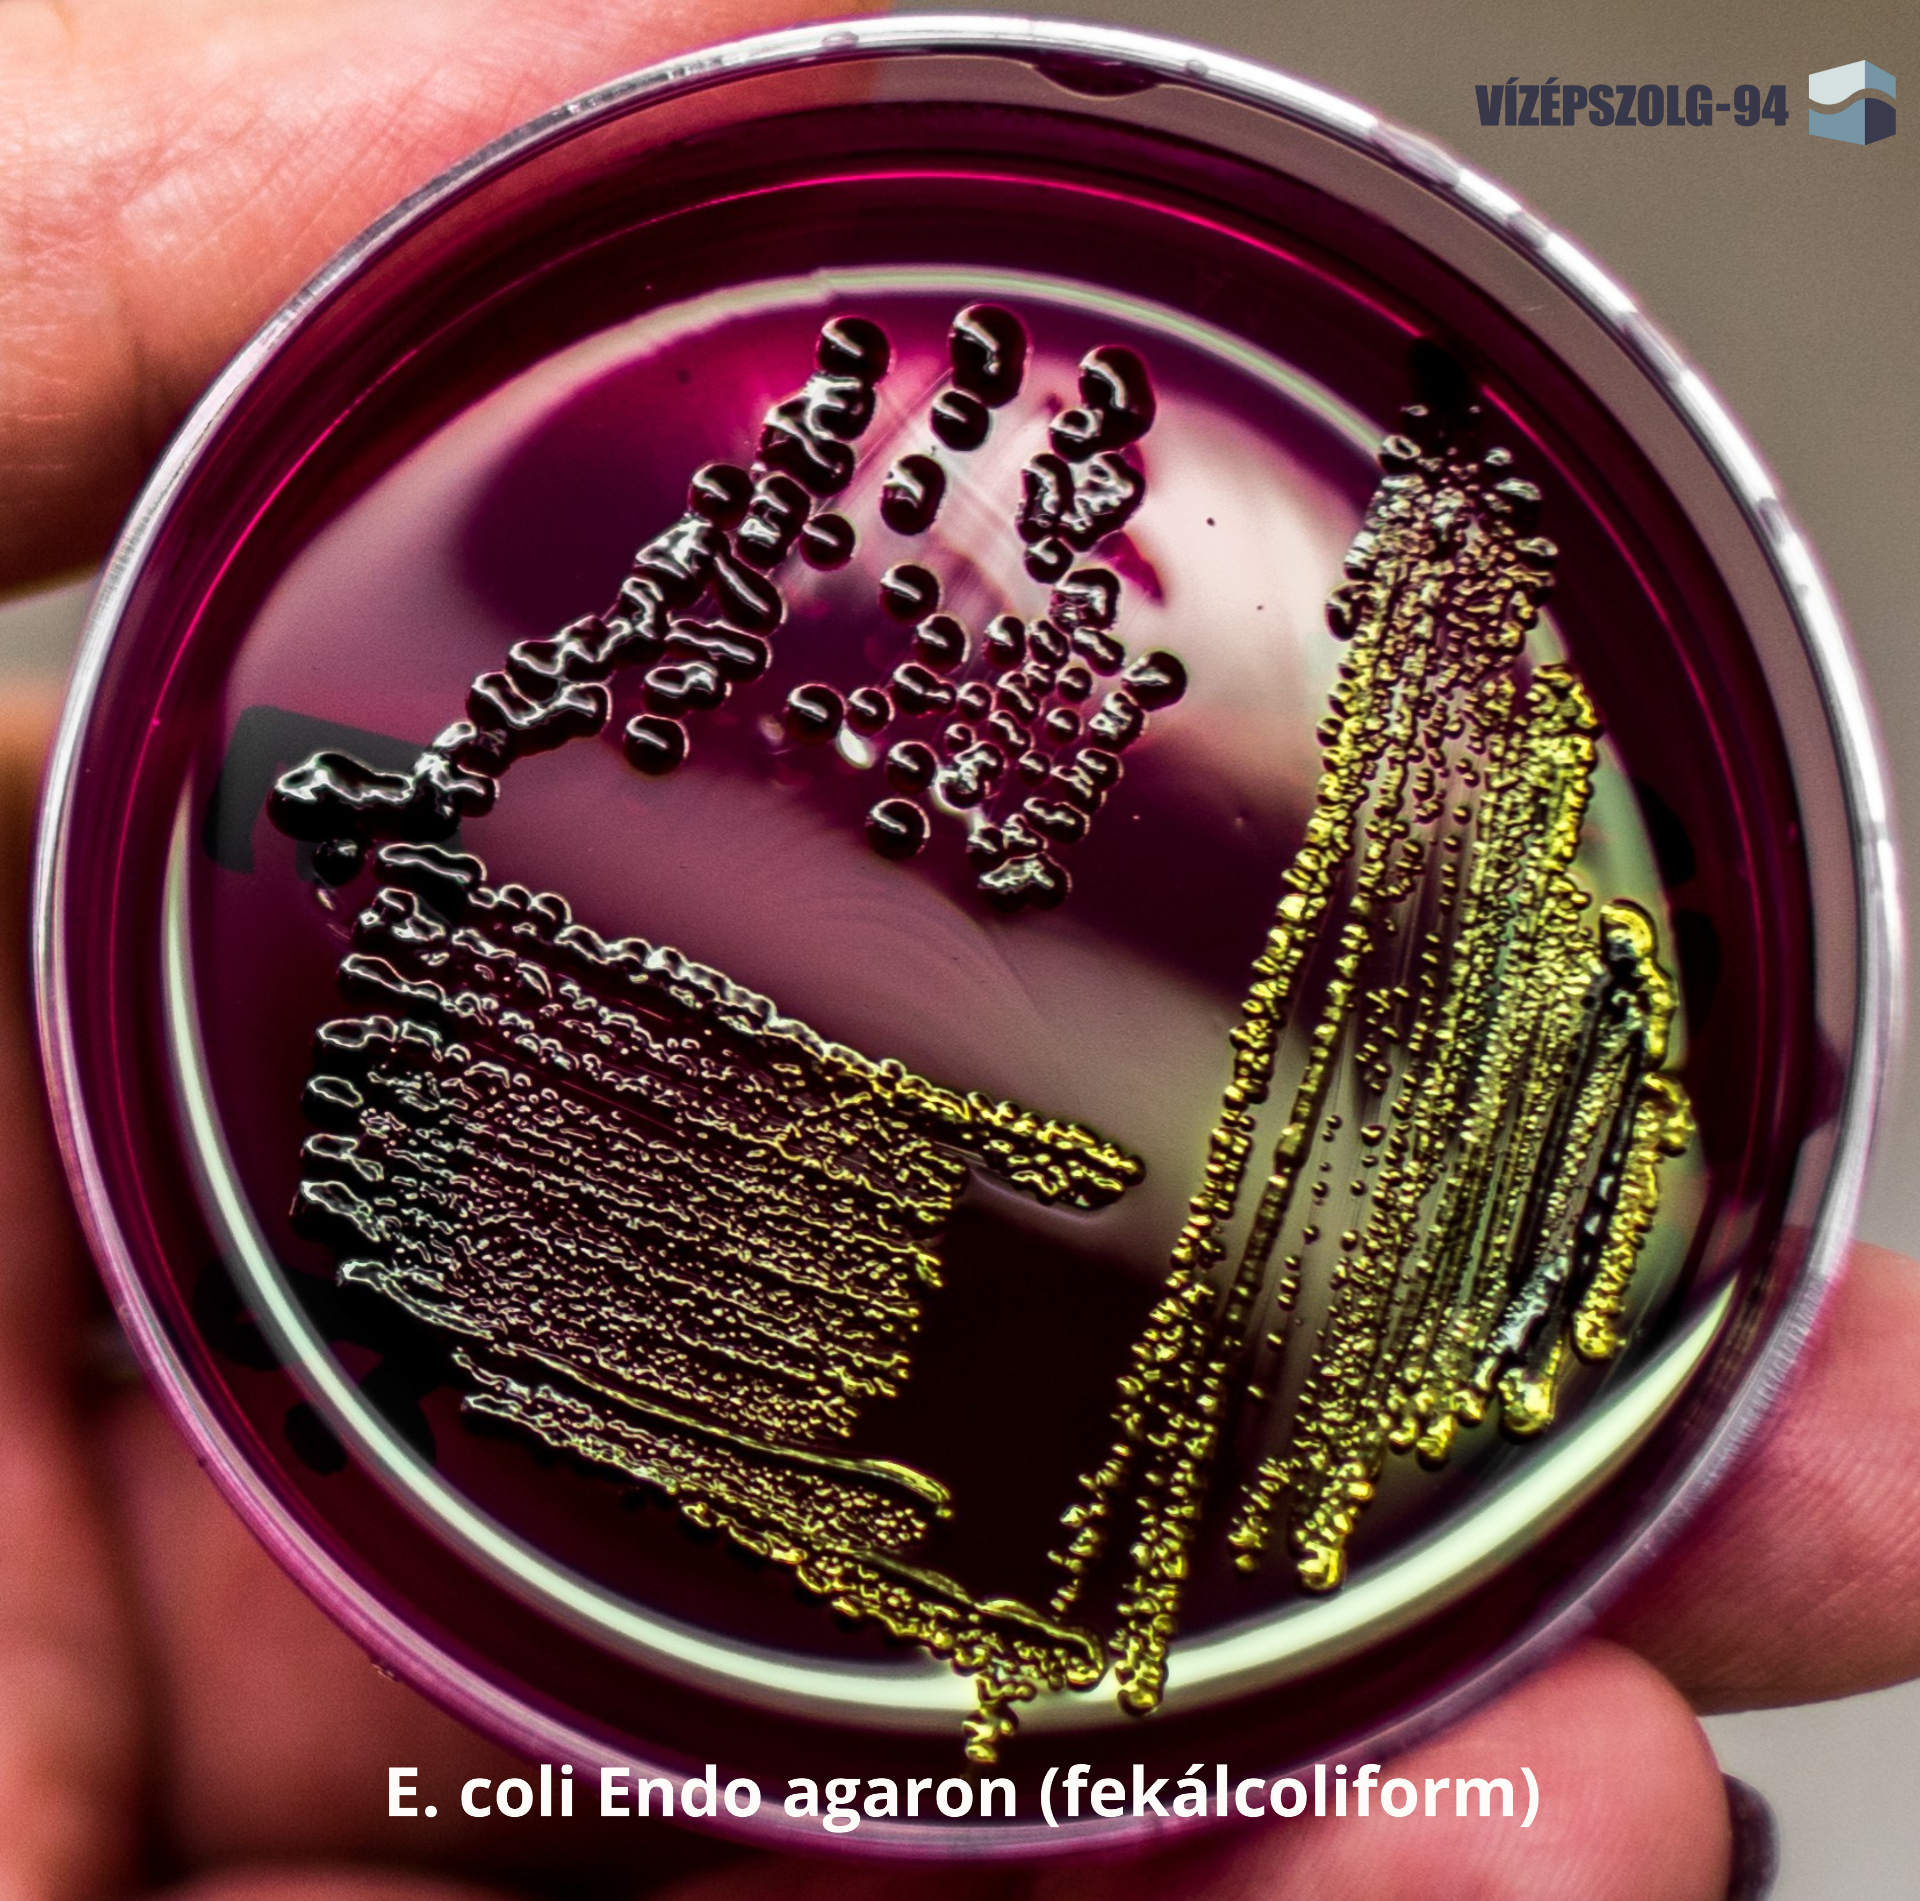

Szennyvíziszap és szennyvíziszap-komposzt vizsgálata
A szennyvíziszap és szennyvíziszap-komposzt mezőgazdasági felhasználása fontos eleme a körforgásos gazdálkodásnak, mivel hozzájárul a talaj tápanyagutánpótlásához, ugyanakkor a potenciális szennyezők miatt szigorú uniós és hazai szabályozás alatt áll.
A szennyvíziszapot a mezőgazdaságban történő felhasználás előtt kezelni kell, hogy csökkenjen a kórokozók és szennyező anyagok mennyisége. A szennyvíziszap-komposzt olyan kezelt iszap, amelyet biohulladékokkal és egyéb adalékokkal komposztálnak, így stabil, talajjavító jellegű anyag jön létre. A komposztálás csökkenti a patogén mikroorganizmusok számát, stabilizálja a szerves anyagokat, mérsékli a szagkibocsátást, könnyebben kezelhető, nagyobb szárazanyagtartalmú anyagot eredményez.
A szennyvíziszap és szennyvíziszap-komposzt mezőgazdasági felhasználását uniós szinten a 86/278/EGK irányelv, hazai szinten első sorban az 50/2001. (IV. 3.) Korm. rendelet szabályozza. A jogszabályok célja, hogy a szennyvíziszap mezőgazdasági felhasználása ne okozzon káros hatást a talajra, növényekre, állatokra és az emberekre, miközben ösztönzik annak hasznosítását.
Alapvető követelmény, hogy csak megfelelően kezelt szennyvíziszap juttatható ki a talajra. A szennyvíziszap mezőgazdasági felhasználása előtt vizsgálni kell az iszap és a fogadó talaj összetételét, különösen a nehézfémek koncentrációját. A jogszabályok meghatározott határértékeket állapítanak meg többek között kadmiumra, rézre, nikkelre, ólomra, cinkre, higanyra és krómra, és rögzítik azt is, hogy ezekből az anyagokból évente mennyi juttatható a talajba.

Részletesen szabályozott az is, hogy milyen területeken és milyen időszakokban tilos a szennyvíziszap kijuttatása. Nem alkalmazható például olyan területeken, ahol közvetlenül fogyasztásra kerülő növényeket termesztenek a betakarítás előtti időszakban, illetve olyan legelőkön, ahol az állatok rövid időn belül legelnek. A szabályozás célja, hogy megelőzze a szennyezőanyagok bejutását az élelmiszerláncba. Emellett figyelembe kell venni a talaj tulajdonságait, a talajvíz védelmét, valamint a környezeti érzékenységet is.
A 50/2001. (IV. 3.) Korm. rendelet nyilvántartási és ellenőrzési kötelezettségeket is előír. A szennyvíziszap termelőjének és felhasználójának dokumentálnia kell az iszap mennyiségét, minőségét, valamint a kijuttatás helyét és idejét. A hatóságok rendszeres ellenőrzésekkel biztosítják, hogy a felhasználás megfeleljen a jogszabályi követelményeknek.
A szennyvíz, szennyvíziszap, szennyvíziszap komposzt mintavételét, valamint az előírt vizsgálatokat csak a mintavételre, illetve a vizsgálatokra akkreditált laboratóriumok végezhetik.
Laboratóriumunk akkreditált területei közé tartoznak a szennyvíziszap, szennyvíziszapból készült komposzt mintavétele, kémiai és bakteriológiai vizsgálatai is.
A szennyvíziszap mintavételét az MSZ EN ISO 5667-13:2012 szabvány szerint végezzük, vevői igények szerint tároló medence, tartály folyékony iszapjából, illetve prizmában, silókban, szikkasztóágyon tárolt víztelenített, szárított iszapból. A szennyvíziszapból készült komposzt mintavétele az MSZ 10-509:1991 4. fejezet szerint történik. Komposztból minden estben átlagmintát veszünk.
A mintaelőkészítés során az elemtartalom meghatározáshoz a mintát salétromsav-hidrogénperoxid elegyével roncsoljuk. A kémiai roncsolás célja, hogy a szilárd mintában jelen lévő komponenseket olyan formába alakítsuk, amelyben analitikailag meghatározhatók. Mivel az induktívan csatolt plazma spektrometria (ICP) csak folyadékfázisú minták vizsgálatára alkalmas, a roncsolás során a mintát a méréshez feltárjuk.
A szennyvíziszap és az abból előállított szennyvíziszap-komposzt vizsgálata során a feltárás kiemelt jelentőségű, mivel ezek az anyagok nagy arányban tartalmaznak szerves összetevőket. A vizsgálni kívánt elemek többsége nem szabad ionos formában található meg, hanem a szerves anyagokhoz kötődve, különféle komplexek részeként, illetve a mikroorganizmusok biomasszájába beépülve van jelen.
A szennyvíziszap és szennyvíziszap-komposzt vizsgálatokat nagyműszerekkel (ICP-OES), kisműszerekkel (potenciometria, spektrofotometria), klasszikus kémiai vizsgálatokkal (roncsolás, titrimetria, tömegmérés) végezzük. A fekálcoliform és fekálstreptococcus számot tenyésztéses bakteriológiai vizsgálattal, többcsöves módszer ellenőrizzük.
A szerves szennyezők vizsgálatát, az erre a területre akkreditációval rendelkező partner laboratóriumunkkal végeztetjük.
Az elvégzett szennyvíziszap és szennyvíziszap-komposzt vizsgálatokról 10-14 munkanapon belül eredménylapot állítunk ki, melyet elektronikusan pdf formátumban továbbítunk az ügyfelek részére. (Kérés esetén postai úton is elküldjük.)
